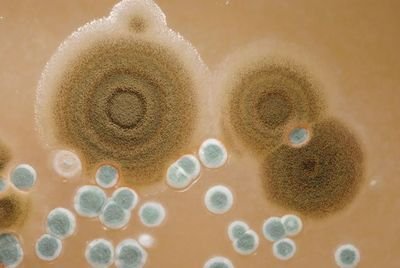
国际空间站“长毛”了，成为超强霉菌的家园，为何难以清除？

以美国为主导、多个国家共同参与建设的国际空间站,从1998年以来在轨道上已经运行20多年了。目前“服役”年限已经超过既定的10-15年时间,可以说“垂垂老矣”。这不,近年来,国际空间站出现了一系列的问题,持续困扰着在空间站上工作和生活的宇航员们。

比如,2018年8月,国际空间站 “联盟MS-09”飞船出现漏气事件,经查在飞船轨道舱的舱壁上,有一个长度近2毫米的裂缝,当时进行了紧急抢修。虽然当时控制住了,但国际空间站漏气事故,始终未能彻底解决。今年8月份,在空间站美国舱段,又发生了漏气,每天泄露的气体总量大约在220克左右。漏气的困扰没有解决,另外一个令人头疼的问题,也始终影响着宇航员们的工作和生活,那就是在国际空间站中出现了超强霉菌,不但在舱壁上能看到霉菌的身影,就连站内的空气中霉菌的含量也超标了。

什么是霉菌?
在日常生活中,我们会经常接触到霉菌,比如在过期的食物表面、在阴暗潮湿的角落,都可以看到成片的黑绿色菌斑。从生物学角度看,霉菌是真菌的一种,是那些能够形成分枝状菌丝真菌种类的统称。

霉菌的菌丝往往特别发达,不过没有像蘑菇那样的较大的子实体,在潮湿的地方,依靠无性或者有性繁殖繁殖方式,在物体上长出菌丝。根据菌丝的功能不同,可以划分为营养菌丝、气生菌丝和生殖菌丝三种,共同形成肉眼可见的絮状、绒状或者蛛网状的菌落群体。

霉菌拥有很强的繁殖能力,其繁殖方式多种多样,菌丝体上的任何一段,都可以在适宜的环境中发展成一个新的个体,这是它们的一种增殖模式。但是在自然状态下,霉菌更多地依靠形成无性或者有性孢子来实现繁殖。其中,通过生殖菌丝分化成的是无性孢子,而通过同一菌丝结合或者不同性菌丝结合,都可以形成“接合”孢子,从而进行有性繁殖。正是由于霉菌的多种生殖方式,使得它们可以根据周围环境的特点,实施各异的繁殖策略,因此只要条件合适,它们的蔓延速度是非常快的。

霉菌还有一个特点,那就是耐受力很强。由于霉菌孢子具有小、轻、干、多的特点,而且还能在环境条件不适宜时进行长时间的休眠,同时可以抵御高低温、强辐射等极端环境的冲击,所以抗逆性很强,在世界很多地方包括太空中都有可能见到它们的身影。

空间站上的超强霉菌
霉菌在地球的绝大多数环境中,都是存在的,可以说只要有人类生活的区域,必然都能符合它们繁殖的标准,所以与人类的关联度和影响非常强。那么,在空气接近真空、微重力以及辐射强度很大的太空环境中,也会有霉菌的存在吗?
答案是肯定的。国际空间站是目前接收宇航员进行太空驻留任务时间最长、次数最多的地外场所,早在2016年时,就在国际空间站的舱壁上发现了霉菌的身影,比如内舱壁上、空气中甚至外舱壁上,都被发现过。
虽然霉菌的个体非常小,但是在数量多、繁殖快、适宜性强等特点的加持下,在空间站中霉菌形成了“规模效应”,不但腐蚀舱壁、污染食物和空气,而且还会对空间站内进行的科学实验、实验植物生长、培育的蔬菜造成严重冲击,甚至还能直接影响宇航员的身体健康,引发诸如呼吸系统、消化系统、神经系统、免疫系统、内分泌系统等方面的疾病。

霉菌为什么能在空间站上生存?
刚才提到了,霉菌在地球上的适应性非常强,只要有人生活的地方,几乎都或多或少地存在着霉菌,在空间站内部,具备着人类长期驻留所需的空气、水和温度条件,而这些条件对于霉菌来说,肯定也再“舒适”不过了。
当宇航员乘坐的载人飞船、或者货运飞船从地球发射出来时,但凡宇航服、物品、仪器设备哪怕是空气中,沾染有少量的霉菌菌丝体或者孢子,都有可能最终在国际空间站内“开枝上叶”。由于菌丝体和孢子非常微小,即使在地面上进行严格的消杀,也做不到将它们完全清除。

国际空间站上最常见的两种霉菌是曲霉菌和青霉菌,有科学家做过实验,将这两种霉菌的孢子样品,完全暴露在太空环境中,让它们经受X射线、伽马射线射线以及高强带电粒子的冲击。一般情况下,生物体内的DNA会在这种环境中,遭到不同程度的破坏,从而使得机体细胞发生死亡。但是霉菌的孢子,却能够抵抗住差不多1000 gray的X射线、3000焦耳/平方米强度的紫外线照射,丝毫不影响它们的活性。

作为对比,0.7gray是宇航员执行半年火星任务所接受到的辐射总量。据科学家推测,霉菌孢子能够承受的宇宙辐射强度,能达到人类致死量的至少200倍以上,可见它们是多么的“变态”。
由于霉菌的孢子具有超强的耐受性和高超的繁殖能力,在执行载人飞行、空间站运行等任务中,人们不得不投入更多的时间、精力和努力,去保持飞船的清洁。在国际空间站中,虽然宇航员们会定期对站内空间和舱壁进行清洁、消杀,但是空气中的霉菌含量目前来看,仍然要高于每立方米100个的安全标准之上,宇航员们不得不长期与霉菌进行斗争。

当然,霉菌在太空中很难被杀死也能带来积极的因素,那就是更容易被携带并参与到相关的太空实验中,可以用来开展研制抗生素、维生素的相关研究,是这些实验不可多得的原料工厂。